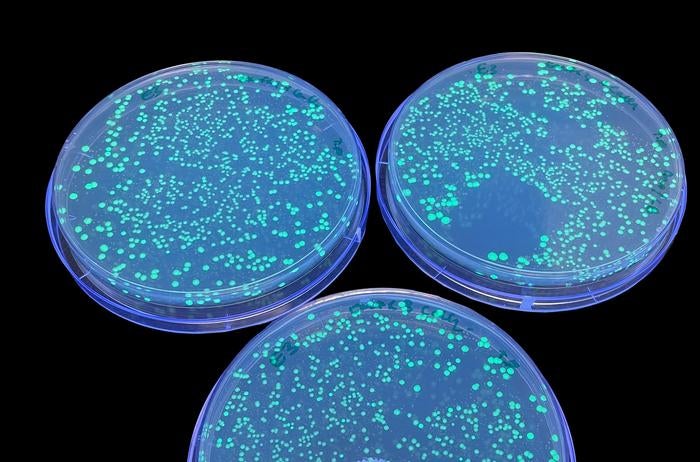
E coli colonies light up green under UV light

Common bacteria could turn plastic waste into painkillers, study finds
Finding could lead to new recycling methods
Scientists have discovered that a strain of common faecal bacteria can convert plastic waste into the drug paracetamol, a finding that could lead to new recycling methods.
Exposure to tiny plastic fragments, called microplastics, is linked to a range of health issues, like hormonal disruption and several types of cancer.
Scientists have been experimenting with various methods to sustainably recycle plastic waste. Of the methods they have tested, the use of bacteria and their enzymes to produce desirable small molecules from plastic waste has shown promise.
Microbes have a “toolbox” of highly active chemicals integral to their metabolism which scientists hope to harness for the production of a range of industrial small molecules.
Using microbes and their metabolic chemicals in different industries could lower the existing chemical manufacturing routes that heavily rely on diminishing fossil fuels.

Scientists have found that a type of chemical reaction which takes place in living cells can be catalysed by phosphate molecules present in the gut bacteria E coli, known to cause urinary tract infections and gastric ailments.
This chemical reaction, known as Lossen rearrangement, produces a type of nitrogen-containing organic compound essential for cell metabolism.
“The reaction occurs in vivo, under ambient conditions, is non-toxic to E coli and is catalysed by phosphate in cells,” scientists explained.
In a study published on Sunday in the journal Nature Chemistry, researchers used various methods to degrade polyethylene terephthalate plastic bottles to produce the starting molecule needed for the Lossen rearrangement chemical reaction. They showed that the metabolic process inside cells could then remediate PET.
Researchers revealed this plastic-derived molecule could be used as a starting material for producing paracetamol in E coli with a 92 per cent yield.
This is the first time paracetamol has been produced from E coli using a waste product.
“The Lossen rearrangement substrate can also be synthesised from polyethylene terephthalate and applied to whole-cell biocatalytic reactions and fermentations generating industrial small molecules, including the drug paracetamol,” scientists said.
Researchers hope the new technique could pave the way for a general strategy to remediate and upcycle plastic waste across ecosystems.
They say the method outlined in the study could lead to better metabolic engineering for manufacturing such nitrogen-containing organic chemicals.
Scientists say further research involving different types of bacteria and plastic may generate other useful products.
“Overall, this work expands the available toolbox of metabolic chemistry for small-molecule synthesis,” they wrote.
Join our commenting forum
Join thought-provoking conversations, follow other Independent readers and see their replies
Comments
Bookmark popover
Removed from bookmarks